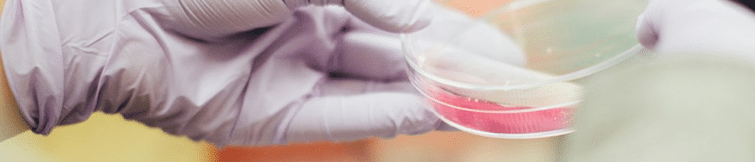
Glove holding a scientific sample

In his first book, Infantile Autism (1964), ARI’s founder and advocate, Dr. Bernard Rimland, posited that behaviors observed in autistic children indicate differences in their underlying biology, likely influenced by genetics, environmental factors, and neurology. His publication emphasized multi-discipline investigation, shifting the focus of autism research to the biomedical track.
For nearly 60 years, ARI’s dedication to transparency, collaboration, independence, and risk-taking has kept us at the forefront of autism research and education. We facilitate cutting-edge biomedical research, disseminate important discoveries to clinicians and families, and bring experts from various fields together to discuss findings and their implications for research and care. With the help of generous donor support, ARI continues to advance autism research and education.
ARI works to support the health and well-being of people affected by autism through innovative, impactful research and free education.
Active years & counting
What We Do
Research Grants
ARI awards grants to fund innovative research that holds realistic promise in impacting the lives of autistic people. ARI has awarded more than 100 research grants over the past 10 years. In 2024, ARI significantly expanded its research funding initiatives. The maximum award per scientific research grant increased to $100,000, empowering more ambitious projects. Overall grant funding grew by nearly 75%, and the number of applications doubled—highlighting a strong surge in innovative proposals and interest from the research community. View ARI-Funded Research Studies from 2024.
Educational Resources
Our free expert-led webinars provide an in-depth look at ongoing research on autism and evidence-based care practices for families and clinicians. Additionally, our Continuing Medical Education series, offered in joint providership with the Cleveland Clinic, details important topics in autism like gastrointestinal issues, healthcare access, and medical challenges.
Scientific Think Tanks
Since 1995, ARI has brought together experts at its annual scientific Think Tank meetings to address novel questions and discuss issues related to promising interventions. Our work has influenced how researchers approach investigating the various issues including appropriate support and guidance for autistic individuals. In 2025, we hosted our 31st annual Think Tank.
Our Global Reach
Creating Lasting Impact Worldwide
Our Global Reach
Creating Lasting Impact Worldwide
Additional Resources We Provide
Autism Treatment Evaluation Checklist

The Autism Treatment Evaluation Checklist, or ATEC, is one of the most widely used assessment tools in the autism community. It is designed to evaluate treatment efficacy and monitor progress over time. The ATEC is used by parents and researchers, schools, clinics, and insurance companies. More than one million ATECs have been completed over the past 20 years.
The Autism Research Review International

The Autism Research Review International (ARRI), ARI’s quarterly journal, keeps you up-to-date with the latest research on autism. The ARRI has received worldwide praise for its thoroughness and objectivity in reporting developments in biomedical and educational research.
Global Outreach & Support

ARI collaborates with non-profits and research organizations worldwide and maintains global support and research networks with members in more than 77 countries.
Monthly Newsletters

The monthly ARI e-newsletter includes news, webinar updates, and autism-related information and articles.
In collaboration with the Schafer Autism Report, ARI publishes a clinical e-newsletter that provides links to up-to-date clinical research related to patient care.
Tissue Bank Support
ARI supports a tissue bank for the National Institute of Child Health and Human Development at the University of Maryland (410-706-1755), the Digestive Function Laboratory Repository at Massachusetts General Hospital in Boston, and a specimen bank for non-autistic individuals which provides proper comparison controls for researchers.

Our Operations
ARI is dedicated to developing a standard of care for individuals with autism spectrum disorders and their families. To do this, we rely on the generosity of donors like you. ARI never accepts funding from government or special interest groups.
Year after year, the Autism Research Institute continues to earn the coveted 4-star rating from Charity Navigator, the Platinum Transparency Seal from Candid/Guidestar, and the Top Rated badge from Great Nonprofits.
“It’s important that our donors continue to trust that we’re using their gifts wisely in order to accomplish our mission to support the health and well-being of people affected by autism through innovative, impactful research and education, These ratings demonstrate our transparency, good governance, and financial accountability.”
Stephen M. Edelson, Ph.D., Chief Science Officer at ARI.
Meet Our Team
The Autism Research Institute (ARI) is a non-profit 501(c)3 organization focused on conducting and sponsoring research aimed at improving the quality of life for today’s generation of children and adults with autism spectrum disorders.
Donations are tax-deductible: Fed ID No. 95-2548452